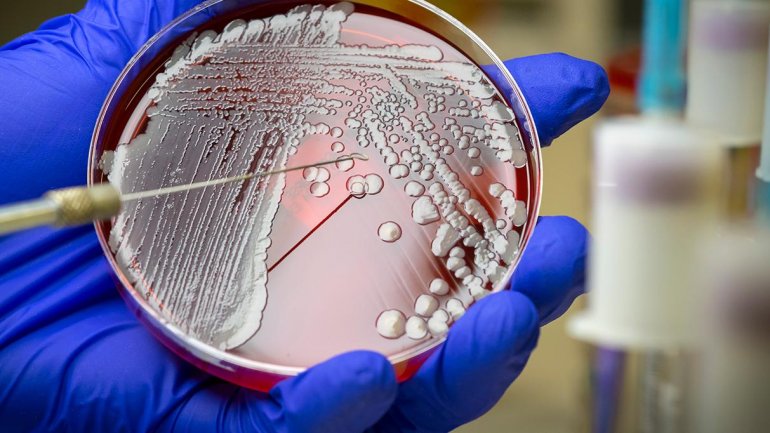

Ζήσης Ψάλλας
Μια μελέτη που δημοσιεύτηκε στο περιοδικό The Lancet Infectious Diseases δείχνει πως το superbug MRSA μπορεί να εισέλθει σε ένα σπίτι και να εξαπλωθεί γρήγορα..
Ο MRSA ήταν κάποτε σπάνια λοίμωξη, αλλά σήμερα έχει γίνει αιτία για πάνω από 20.000 θανάτους στις ΗΠΑ. Μολύνει πολλές εκατοντάδες χιλιάδες Αμερικανούς κάθε χρόνο και είναι δύσκολο να αντιμετωπιστεί επειδή δεν ανταποκρίνεται καλά στα χρησιμοποιούμενα αντιβιοτικά.
Η μελέτη εξέτασε 150 παιδιά χωρίς προφανείς ιατρικές παθήσεις και τις οικογένειές τους. Τα παιδιά είχαν διάμεση ηλικία 3 ετών. Όλα είχαν υποβληθεί σε θεραπεία για λοιμώξεις από σταφυλόκοκκο κατά την περίοδο 2012 έως 2015. Τα μέλη της οικογένειάς τους αριθμούσαν περίπου 700 άτομα και υπήρχαν πάνω από 150 κατοικίδια ζώα, είτε γάτες είτε σκύλοι.
Σε κάθε σπίτι έγιναν πέντε επισκέψεις για ένα έτος. Οι συμμετέχοντες απάντησαν σε περισσότερες από 100 ερωτήσεις σχετικά με την υγιεινή τους και άλλες προσωπικές συνήθειες. Σε κάθε επίσκεψη, οι ερευνητές πήραν δείγματα από το εσωτερικό κάθε πλευράς της μύτης, τις μασχάλες και τη βουβωνική χώρα στους ανθρώπους, καθώς και από τη μύτη και τις πλάτες των ζώων. Έλαβαν επίσης επιχρίσματα από 21 οικιακές επιφάνειες που συνήθως αγγίζονται, συμπεριλαμβανομένων των λαβών ψυγείων, νεροχύτη, πάγκων από μπάνια, σεντόνια, πετσέτες, ηλεκτρικούς διακόπτες, τηλέφωνα, τηλεοράσεις ή τηλεχειριστήρια και περιφερειακά υπολογιστών όπως το ποντίκι και το πληκτρολόγιο.
Οι ερευνητές διαπίστωσαν ότι περίπου στους μισούς ανθρώπους και στο 33% των κατοικίδιων ζώων ο MRSA ήταν παρών σε τουλάχιστον ένα δείγμα κατά τη διάρκεια της περιόδου μελέτης. Συνολικά, σχεδόν 1.300 περιπτώσεις MRSA προέκυψαν. Ήταν ιδιαίτερα ενδιαφέρον ότι η παρουσία του MRSA ήταν χαμηλότερη σε γάτες και σκύλους από ό, τι στους ανθρώπους.
Οι επιστήμονες ανέλυσαν τις συνήθειες υγιεινής για να διαπιστώσουν ποιες από αυτές σχετίζονται με την είσοδο του βακτηρίου στο νοικοκυριό και βρήκαν μερικές σημαντικές τάσεις:
- Η συχνή πλύση των χεριών πριν και μετά τη χρήση της τουαλέτας, πριν από το φαγητό, πριν από το μαγείρεμα και μετά την αλλαγή της πάνας ενός μωρού, χρησιμοποιώντας σαπούνι ή απολυμαντικό χεριών, συσχετίστηκε με χαμηλότερο κίνδυνο εισόδου του βακτηρίου στο σπίτι.
- Η παρουσία παιδιών αύξησε τις πιθανότητες λήψης του βακτηρίου.
Οι ερευνητές διαπίστωσαν ότι το MRSA εξαπλώθηκε πιο συχνά στις ακόλουθες περιπτώσεις:
- Όταν οι οικιακές επιφάνειες ήταν πολύ μολυσμένες.
- Όσο λιγότερο καθαρό το σπίτι, όπως εκτιμήθηκε από την προφανή οσμή, την ακαταστασία και τις βρώμικες επιφάνειες, τόσο πιο πιθανό ήταν να εξαπλωθεί το βακτήριο από το ένα άτομο στο άλλο.
- Τα νοικιασμένα σπίτια με πολλά άτομα ήταν πιο πιθανό να έχουν υψηλότερα ποσοστά διάδοσης.
- Η κοινή χρήση υπνοδωματίων, κρεβατιών, πετσετών και οποιουδήποτε είδους αντικειμένων που χρησιμοποιούνται για προσωπική υγιεινή συσχετίστηκε με μεγαλύτερο κίνδυνο εξάπλωσης.









